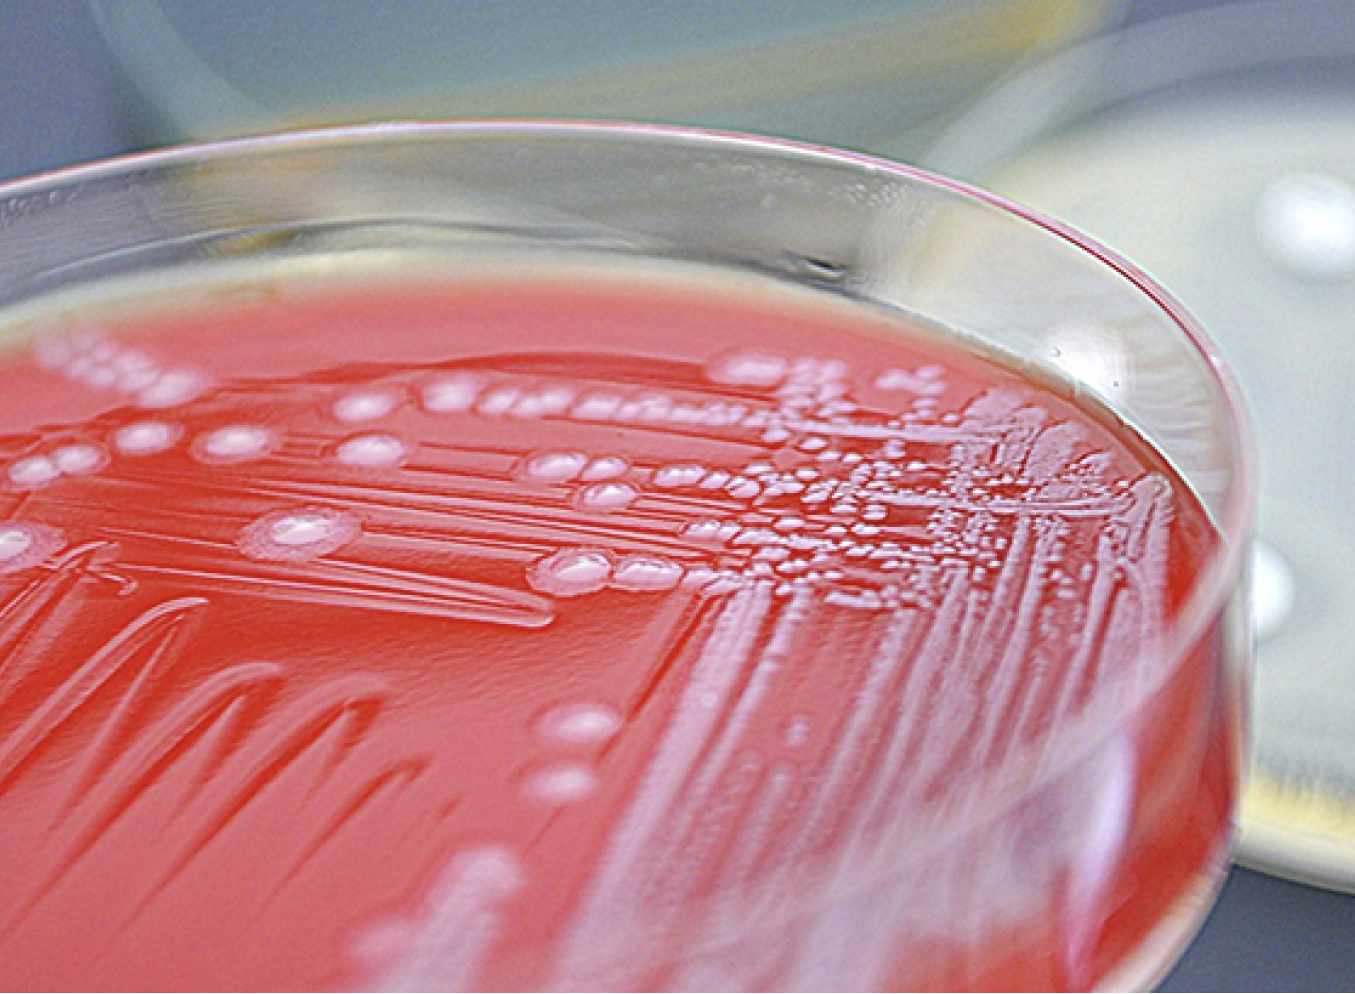

Whether it is caring for patients with infections such as HIV, tuberculosis, or Valley fever, conducting research or antimicrobial stewardship (promoting the appropriate use of antibiotics), antifungals, and antivirals, the Infectious Diseases (ID) Fellowship Program at UCSF Fresno exposes fellows to a comprehensive outpatient and inpatient clinical training and research opportunity.
The infectious diseases fellowship is right for you, “if you want a real-world experience and make a difference in infectious disease,” says UCSF Fresno ID Fellowship Program Director Hebah Ghanem, MD.
The two-year ACGME-accredited program, established in 2008, matches two PGY-4 fellows each year, preparing them for careers in academic medicine, hospital infection control/antimicrobial stewardship and private practice. Fellows spend one year training at Community Regional Medical Center (CRMC), one of California’s busiest medical centers and the only trauma center and burn unit between Sacramento and Los Angeles. They spend six months at the VA Central California Health Care System and another six months for research and antimicrobial stewardship at CRMC and Clovis Community Medical Center (CCMC).
Fellows also acquire outpatient and continuity of care experience at Community Medical Centers Special Services HIV clinic, providing services to nearly 1,500 patients for HIV, AIDS, and for opportunistic infections by organisms that normally do not cause disease but that occur in people with weakened immune systems.
“We offer medical service for a large population, and that is one thing that makes our program robust and strong for clinical training and educational experience for those who are looking for academic service, “ says Dr. Ghanem, who herself was a UCSF Fresno ID fellow and stayed to teach as UCSF health sciences assistant clinical professor for infectious diseases at the regional campus in Fresno.
The UCSF Fresno ID Fellowship Program also has a strong infection control focus. Fellows participate in caring for complex hospital cases while working alongside dedicated faculty.
A distinctive highlight of the ID fellowship program is its well-established antimicrobial stewardship at CRMC, CCMC, and Fresno Heart & Surgical Hospital. “It’s a privilege for a hospital to have an antimicrobial stewardship,” Dr. Ghanem says. Fellows work in a team to review antibiotic prescriptions. The ID team includes a fellow, an attending physician (ID faculty), and a pharmacist.
In addition to patient care, research is a growing component of the ID fellowship. Fellows are given time for research and quality improvement (QI) projects, and they work alongside faculty experts who are leading research for various infectious diseases. “Our fellows have been accepted for abstracts by IDSA (Infectious Diseases Society of America) for the last four years, and our second-year fellow is presenting this October at IDSA week,” says Dr. Ghanem.
UCSF Fresno encourages research that is particularly relevant to the San Joaquin Valley, and this includes coccidioidomycosis (Valley fever), a fungal infection endemic to the central region of California. Geetha Sivasubramanian, MD, chief of the UCSF Fresno Division of Infectious Diseases and UCSF Health Sciences Associate Clinical Professor, is nationally recognized for her expertise in Valley fever. Last year, Dr. Sivasubramanian was invited by the federal Centers for Disease Control and Prevention to participate in the CDC’s Fungal Disease Awareness Week to provide information about real-life cases, diagnostic challenges, and best practices for early detection and treatment.
Fellows also collaborate with faculty experts in other specialties, such as hematology-oncology, burn, trauma, and surgery, in a multidisciplinary approach for infection prevention and control.
Teaching opportunities are part of the fellowship, as fellows are assigned to Internal Medicine residents completing their ID rotation. The fellows and residents discuss infectious disease cases together with an attending physician.
The exposure to teaching, research and patient care provides fellows with the knowledge of what they want to do upon completing fellowship training, Dr. Ghanem says. “Some of our graduates go to private work, and some even specialize, for example, in orthopaedic ID, and there are others who have built their own antimicrobial stewardship just from how they were trained here.”
Three of the current ID faculty at UCSF Fresno, in addition to Dr. Ghanem, were fellows of the program and stayed to teach. They are Nancy Dang, MD; Michele Maison-Fomotar, MD, who is the associate program director; and Jessica Mcfarland, MD.
“This reflects on how strong our program is,” Dr. Ghanem says. “I am originally from Orange County (in California) and have all my family there. So, when I did residency in New Jersey, my goal always was to go back to Orange County, but when I applied here for fellowship, the whole interview environment, the collegial environment, made me choose this program as my No. 1 to go to.”
During her interviews for a fellowship at UCSF Fresno, Dr. Ghanem says she found values that aligned with hers. “It’s what we offer for the patients, and the patients usually are very grateful for what we do.”
It’s a challenging program, which also attracted her, she says. “I have never ever seen the variety of pathology I see here. We have patients who have more than one infection at one time. My interests are antimicrobial stewardship and immunosuppression, but also tuberculosis, and we have seen a huge number of TB cases in this area, and not just the regular TB, the resistant infection.”
Dr. Ghanem says the UCSF Fresno ID Fellowship Program is tight knit. “We are like a family. We have good relationships with each other, as attendings, and we have good relations with the fellows.”
Applying for the program
The UCSF Fresno Infectious Diseases Fellowship Program participates in the National Resident Matching Program (NRMP). All applications are handled through the Electronic Residency Application Service (ERAS) sponsored by the Association of American Medical Colleges.
Established in 1975, UCSF Fresno is celebrating 50 years of training doctors and improving health in the San Joaquin Valley this year. A regional campus of the UCSF School of Medicine, UCSF Fresno offers training in eight medical residency programs, one dental surgery residency program and 20 Accreditation Council on Graduate Medical Education (ACGME) and non-ACGME sub-specialty fellowships. UCSF Fresno plays a vital role in expanding access to health care in the Valley, training physicians and medical students for the region and state, conducting research that addresses regional health issues, and academically preparing students from the San Joaquin Valley to pursue careers in health and medicine.